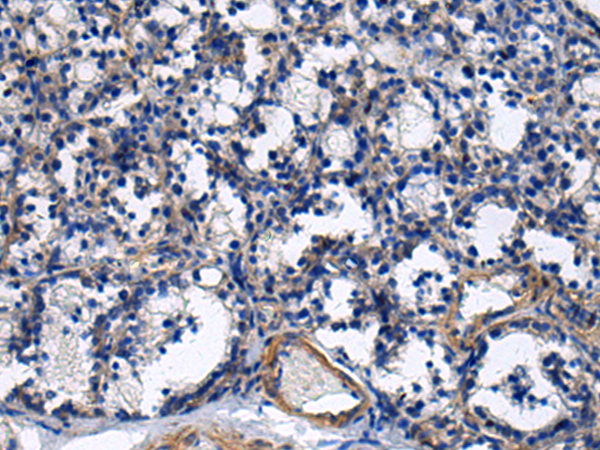

手機掃碼訪問本站

微信咨詢
中文名稱: 兔抗NAA60多克隆抗體
英文名稱: Anti-NAA60 rabbit polyclonal antibody
別 名: HAT4; NAT15
相關類別: 一抗
抗 原: NAA60
儲 存: 冷凍(-20℃)
宿 主: Rabbit
反應種屬: Human, Mouse, Rat
標 記 物: Unconjugate
克隆類型: rabbit polyclonal
技術規格
|
Background: |
Histone acetyltransferase localized in the Golgi apparatus that mediates acetylation of free histone H4, thereby facilitating nucleosome assembly. Has a preference for free histone H4 'Lys-20'(H4K20ac), 'Lys-79'(H4K79ac) and 'Lys-91' (H4K91ac). Also displays alpha (N-terminal) acetyltransferase activity towards a range of N-terminal sequences including those starting with Met-Lys, Met-Val, Met-Ala and Met-Met. Required for normal chromosomal segregation during anaphase. |
|
Applications: |
ELISA, IHC |
|
Name of antibody: |
NAA60 |
|
Immunogen: |
Full length fusion protein |
|
Full name: |
N(alpha)-acetyltransferase 60, NatF catalytic subunit |
|
Synonyms: |
HAT4; NAT15 |
|
SwissProt: |
Q9H7X0 |
|
ELISA Recommended dilution: |
5000-10000 |
|
IHC positive control: |
Human esophagus cancer and Human prostate cancer |
|
IHC Recommend dilution: |
25-100 |